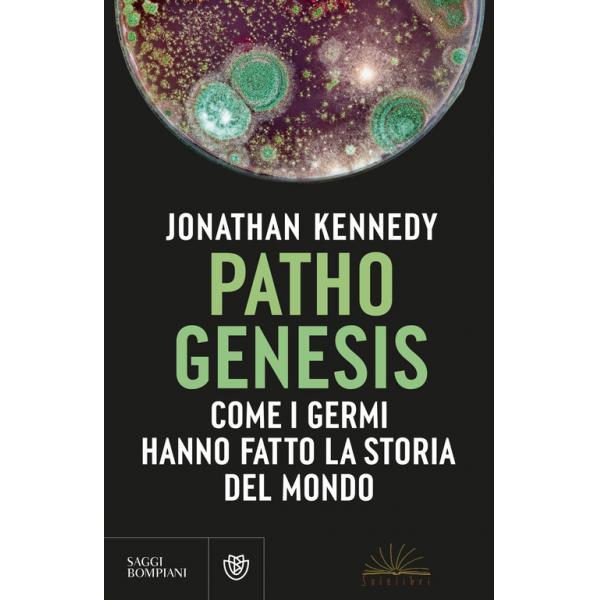

Evoluzione
La straordinaria storia della vita. Dalle prime...
a partire da
Prezzo
6,50 €
Disponibile subito
Costruire la vita. Quattro miliardi di anni dai...
Prezzo
28,00 €
Disp. in 3/4 gg lavorativi